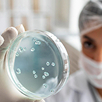
Косметические лактобактерии

- Наши площадки
- Dahlia
- AQUAVIVA S.R.L.
- Сибирский производственно-логистический комплекс
- NamAgroTech
- О нас
- Партнерство
- Контакты
От разработки рецептуры до регистрации
Команда со 150-летним производственным опытом готова создать продукт с нуля и выпустить его под торговой маркой заказчика. 4 отдела Research & Development ежедневно проводят исследования, изучают сотни компонентов и рецептур чтобы создавать новые эффективные продукты с доказанным действием. Мы гарантируем прозрачность процесса и предоставляем возможность осуществлять полный контроль на каждом этапе.
-
01 Исследуем и проектируем
-
Проводим
комплексный анализ рынка и продуктовых трендов, формируем гипотезы и концепции на основе данных
-
Подбираем
активные компоненты, определяем оптимальные формы выпуска и разрабатываем техническое задание на рецептуру и производство
-
-
02 Разрабатываем и тестируем
-
Накапливаем опыт
Специалисты Компании непрерывно накапливают опыт как производства продуктов по рецептурам, так и разработки новых решений под ключ
-
Решения под ключ
начиная с исследований и заканчивая продвижением готовых продуктов на рынке
-
-
03 Производим и контролируем
-
Оптимальная загрузка
производственных мощностей в Сибири, Восточной и Западной Европе и Азии
-
Доступные продукты
это позволяет создавать продукты, максимально доступные для потребителя, поддерживать широкий ассортимент форм выпуска и увеличивать скорость доставки
-
-
04 Упаковываем и доставляем
-
Разрабатываем
конструкцию и дизайн упаковки с учётом логистики, требований устойчивости и нормативных ограничений
-
Обеспечиваем
маркировку и комплаенс под целевые рынки, организуем поставки и таможенное сопровождение
-
5 шагов от идеи к продукту
-
01
Разработка идеи Изучаем тенденции, а также потребности современного человека в сфере здорового образа жизни, спорта и красоты, чтобы предложить максимально эффективный и актуальный продукт.
-
02
Отбор компонентов Вместе с мировыми производителями ключевых компонентов ищем максимально инновационные и безопасные ингредиенты, чтобы гарантировать высочайшее качество и эксклюзивность продукта.
-
03
Селекция прототипов В собственных высокотехнологичных лабораториях разрабатываем рецептуры продуктов, чтобы найти решение, максимально отвечающее запросам клиентов, проводим тесты продуктов на стабильность и эффективность.
-
04
Контроль качества Изучаем свойства продукта в разных условиях и на разных этапах хранения, выбираем максимально безопасные консерванты, чтобы обеспечить безопасность и эффективность продукта в течение всего срока годности.
-
05
Регистрация и выпуск Проверяем продукт на соответствие законам каждой страны, в которой он будет продаваться, чтобы продукт получил одобрение надзорных органов, а Клиент получил его без изменений и адаптаций.
Широкий ассортимент форматов и категорий
Точный формат ваших продуктов можете согласовать с менеджером или указать в заявке на контрактное производство.
-

Биологически активные добавки к пище
Витаминно-минеральные комплексы, ПНЖК, экстракты растений
Таблетки Капсулы Банки Порошки Коробки Блистеры Флоупаки Флаконы -

Спортивное и функциональное питание и напитки
Протеины и аминокислоты, сухие смеси, чаи, полезные снеки
Дойпаки Стики Фильтр-пакеты Батончики Мармелад Драже Леденцы -

Косметические и парфюмерные продукты
Кремы, гели, шампуни, зубные пасты, бальзамы, парфюм
Тубы Банки Флаконы Дозаторы Дезодоранты Пенообразователи
Идеальные ингредиенты
Наши поставщики – крупнейшие производители сырья и биологически активных компонентов. Выбирая партнеров во всем мире – от Франции до Южной Кореи, от Германии до Японии, – мы доверяем исключительно репутации и стабильному качеству лидеров рынка.
Наукоемкие технологии в разработке продуктов
Мир не стоит на месте – каждые несколько лет на рынке появляются новые решения в области применения биологически активных веществ. Наша команда следит за трендами и стремится использовать в разработке и производстве продуктов актуальные технологии.
-

Vcaps® – кошерно, халяльно, по-вегански
Капсулы Vcaps® – идеальные оболочки для чистых продуктов Siberian Wellness. Сделаны на основе растительных компонентов, имеют сертификаты кошерности и халяльности, а также одобрены вегетарианским и веганским сообществами. Технология компании Lonza.
-

Гиалуроновая кислота – главный anti-age агент века
Мы используем гиалуроновую кислоту различных молекулярных масс (от 2 до 3000 килодальтонов) с клинически подтвержденными свойствами (ExceptionHYAL® Full, ExceptionHYAL Relief®, PrincipHYAL AURORА®), чтобы добиться адресного проникновения в кожу для максимального увлажнения и поддержания уровня коллагена и эластина.
-
Косметические лактобактерии – тренд в поддержании красоты
Биотехнология для косметических средств на основе пре- и пробиотиков, лизаты бактерий. Подтверждение селективности роста благоприятной экофлоры. Мощные косметические пребиотики, которые за счет избирательной стимуляции усиливают рост и метаболическую активность «хороших» микроорганизмов на фоне сокращения числа «плохих».
-

Технология IntroVIT – продлеваем жизнь витаминов
Контролируемая технология включения витаминов в готовые продукты (сиропы, таблетки) с учетом термостабильности. Так мы даем гарантированное количество витаминов на протяжении всего срока годности продукта.
-

Flutex™ – трижды очищенная омега-3
Для получения сверхочищенных омега-3 кислот используется технология зеленой химии Flutex – экстракция с помощью CO₂ в сверхкритическом состоянии, очистка и концентрация омега-3 кислот. Flutex дает уникальную возможность получать более концентрированные продукты и исключает использование токсичных органических растворителей, используемых в традиционных методах экстракции. Технология компании Solutex.
Нужна консультация?

Cпасибо за обращение!
Ваш запрос успешно отправлен – команда уже приступила к его обработке.

Запрос временно недоступен
Сейчас возникли временные сложности с отправкой формы. Пожалуйста, повторите попытку через несколько минут.

















